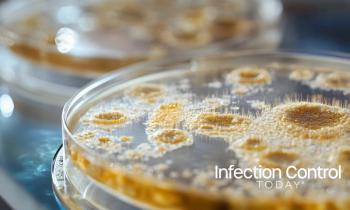
Close-up of petri dishes with fungal cultures for scientific microbiology and research. (Adobe Stock 1467220225 by Tithi)

Infection prevention may be built on evidence, but it thrives on empathy. During a recent Infection Control Today roundtable, in this third installment, veteran infection preventionists shared how emotional intelligence, communication, and systems thinking—not just clinical expertise—define the profession’s future.